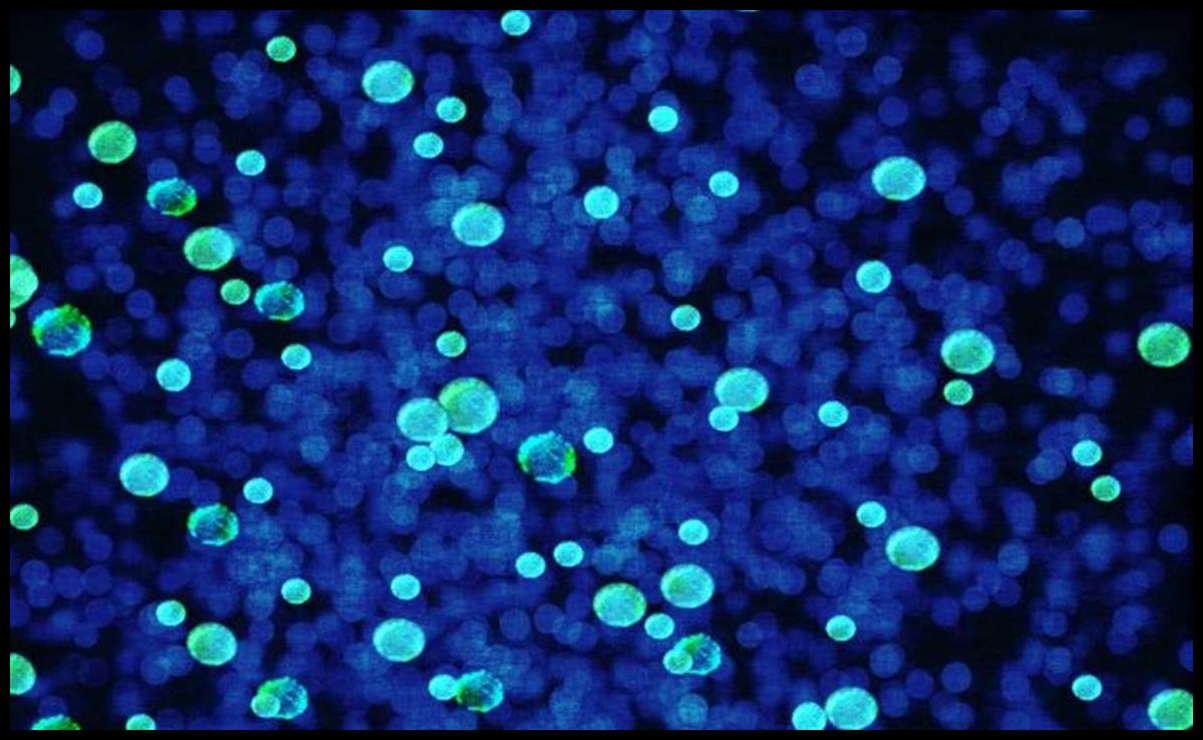

وبحسب الدراسة الجديدة التي أشارت إليها مجلة “نيتشر” العلمية، فإن هذا النوع من البكتيريا يستفيد من غاز كبريتيد الهيدروجين السام كمصدر للطاقة.
وأظهرت الدراسة، التي قادها باحثان من جامعة فيينا، أن هذه البكتيريا قادرة على إزالة السموم من بيئتها وتحويلها إلى مركبات غير ضارة، ما يجعلها عاملا بيئيا طبيعيا في حماية النظم البيئية البحرية والمستنقعات.
علماء روس يثبتون قدرة البكتيريا على تحسين التربة
وأوضح العلماء أن العملية البيولوجية التي تنفذها البكتيريا تقوم على أكسدة الكبريتيد واستخدام أكسيد الحديد الثلاثي (الصدأ) بديلا للأوكسجين، في تفاعل يعيد تدوير العناصر ويحد من انتشار “المناطق الميتة” الخالية من الأوكسجين في البحار والبحيرات.